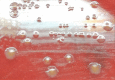

Clostridium ramosum rapidly identified by MALDI-TOF MS. A rare gram-variable agent of bacteraemia
- PMID: 32974599
- PMCID: PMC7497826
- DOI: 10.1099/acmi.0.000137
Clostridium ramosum rapidly identified by MALDI-TOF MS. A rare gram-variable agent of bacteraemia
Abstract
Clostridium ramosum is an enteric anaerobic, endospore-forming, gram-positive rod with a low GC content that is rarely associated with disease in humans. We present a case of C. ramosum bacteraemia. To the best of our knowledge, this is the second case of C. ramosum bacteraemia in an elderly patient presenting with fever, abdominal pain and bilious emesis. We highlight the Gram stain variability, the lack of visualization of spores and the atypical morphology of the colonies that showed C. ramosum in a polymicrobial presentation that initially appeared to show monomicrobial bacteraemia. The microorganism was rapidly identified by matrix-assisted laser desorption/ionization time-of-flight mass spectrometry (MALDI-TOF MS). We present a comprehensive literature review of 32 cases of clinical infections by C. ramosum in which we describe, if available, sex, age, clinical symptoms, predisposing conditions, other organisms present in the blood culture, other samples with C. ramosum , identification methodology, treatment and outcome.
Keywords: Antimicrobial susceptibility; Bacteraemia; Clostridium ramosum; Erysipelatoclostridium ramosum; Infection; MALDI-TOF MS.
© 2020 The Authors.
Conflict of interest statement
The authors declare that there are no conflicts of interest.
Figures
References
-
- Holdeman LV, Cato EP, Moore WEC. Clostridium ramosum (Vuillemin) comb. nov.: emended description and proposed neotype strain. Int J Syst Bacteriol. 1971;21:35–39. doi: 10.1099/00207713-21-1-35. - DOI
-
- Alexander CJ, Citron DM, Brazier JS, Goldstein EJ. Identification and antimicrobial resistance patterns of clinical isolates of Clostridium clostridioforme, Clostridium innocuum, and Clostridium ramosum compared with those of clinical isolates of Clostridium perfringens. J Clin Microbiol. 1995;33:3209–3215. doi: 10.1128/JCM.33.12.3209-3215.1995. - DOI - PMC - PubMed
Publication types
LinkOut - more resources
Full Text Sources
Miscellaneous